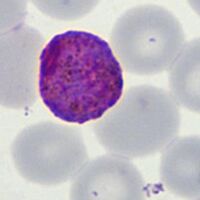
Large macrogametocyte fills red cell
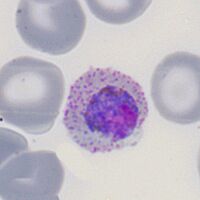
Small round parasite with prominent James' dots

Gallery of gametocytes
From MalariaETC
Navigation
>Main Malaria Index
>>Galleries Index Page
>>>Current page: Gallery of gametocytes
Gallery of Gametocytes
Gametocytes essentially have "microgametocyte" (male) or "macrogametocyte" (female) appearance. For most species the gametocyte is round or slightly angular with species differences mainly reflected in the size of the red cell or parasite, although red cell dots may be seen in P.vivax or P.ovale. The exception is the P.falciparum parasite that has an elongated rod form that may become curved by the residual erythroid membrane - sometimes called the "banana" form..
P.falciparum
Rod shaped gametocytes may be straight and blunt (mainly the shorter "microgametocytes" which may also have darker colour) or curved by the red cell membrane producing a curved and more pointed end (banana form). Pigment generally overlies the central chromatin area.
-
Macrogametocyte, curved by the red cell membrane
-
Microgametocytes, a blunt rod, red cell membrane is "floppy"
-
A more sharp-ended curved macrogametocyte
"
P.vivax
As with other forms in this species parasites and infected red cells are characteristically large; Schüffner's may be seen or hidden by the parasite for macrogametocyte forms. Parasites may have an irregular shape; pigment distribution is diffuse. Images show a maturing sequence.
-
A large and irregular macrogmetocyte
-
Large macrogametocyte fills red cell
-
Microgametocytes with Schüffner's dots visible in red cell cytoplasm
"
P.ovale
Similar to P.vivax but generally smaller and the red cell will often show features such as James' dots, fimbriation and ovoid shape. Pigment tends to be around the circumference of the parasite.
-
Elongated and ovoid red cell contains the parasite
-
Small round parasite with prominent James' dots
-
A more typically ovoid form
-
Round parasite note the pigment around the circumference
"
P.malariae
Small and neat parasites that do not fill the the red cell. Neat pigment around the parasite circumference, Zeimann's dots rarely seen.
-
Small round with circumferential pigment
-
A neat round, possible macrogametocyte form
-
Very small and red cell parasite (possible microgametocyte)
-
Small gametocyte, possibly a second ring form within the cell
"
P.knowlesi
Gametocytes are most similar in appearance to P.malariae. Small and generally round.
-
Small and slightly degenerate gametocyte
-
Similar appearance note small size and absent dots